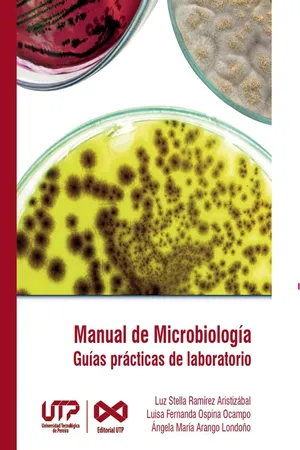
Manual de Microbiología, guías prácticas para laboratorio

eBook - PDF
Manual de Microbiología, guías prácticas para laboratorio
- 145 páginas
- Spanish
- PDF
- Disponible en iOS y Android
eBook - PDF
Manual de Microbiología, guías prácticas para laboratorio
Descripción del libro
En el momento donde se hace necesario migrar a la virtualidad, surge como una oportunidad de innovación en el laboratorio la creación de un manual no sólo de prácticas académicas, relacionadas con fundamentos generales de microbiología, sino una publicación que implementa metodologías para la solución de casos mediante softwares o simuladores virtuales, que complementan el aprendizaje basado en problemas a la vez que promueve el uso de una segunda lengua. Cada capítulo está compuesto por la fundamentación teórica, el protocolo a seguir en el laboratorio, un resumen gráfico, preguntas relacionadas con la práctica y una actividad interactiva.
Cuenta con la confianza de 375,005 estudiantes
Acceso a más de 1 millón de títulos por un precio mensual asequible.
Estudia de forma más eficiente usando nuestras herramientas de estudio.
Información
Categoría
Ciencias biológicasCategoría
MicrobiologíaÍndice
Preguntas frecuentes
Sí, puedes cancelar tu suscripción en cualquier momento desde la pestaña Suscripción en los ajustes de tu cuenta en el sitio web de Perlego. La suscripción seguirá activa hasta que finalice el periodo de facturación actual. Descubre cómo cancelar tu suscripción
No, los libros no se pueden descargar como archivos externos, como los PDF, para usarlos fuera de Perlego. Sin embargo, puedes descargarlos en la aplicación de Perlego para leerlos sin conexión en el móvil o en una tableta. Descubre cómo descargar libros para leer sin conexión
Perlego ofrece dos planes: Essential y Complete
- El plan Essential es ideal para los estudiantes y los profesionales a los que les gusta explorar una amplia gama de temas. Accede a la biblioteca Essential, con más de 800 000 títulos de confianza y superventas sobre negocios, crecimiento personal y humanidades. Incluye un tiempo de lectura ilimitado y la voz estándar de «Lectura en voz alta».
- Complete: perfecto para los estudiantes avanzados y los investigadores que necesitan un acceso completo sin ningún tipo de restricciones. Accede a más de 1,4 millones de libros sobre cientos de temas, incluidos títulos académicos y especializados. El plan Complete también incluye funciones avanzadas como la lectura en voz alta prémium y el asistente de investigación.
Somos un servicio de suscripción de libros de texto en línea que te permite acceder a toda una biblioteca en línea por menos de lo que cuesta un libro al mes. Con más de un millón de libros sobre más de 990 categorías, ¡tenemos todo lo que necesitas! Descubre nuestra misión
Busca el símbolo de lectura en voz alta en tu próximo libro para ver si puedes escucharlo. La herramienta de lectura en voz alta lee el texto en voz alta por ti, resaltando el texto a medida que se lee. Puedes pausarla, acelerarla y ralentizarla. Obtén más información sobre la lectura en voz alta
¡Sí! Puedes usar la aplicación de Perlego en dispositivos iOS y Android para leer cuando y donde quieras, incluso sin conexión. Es ideal para cuando vas de un lado a otro o quieres acceder al contenido sobre la marcha.
Ten en cuenta que no será compatible con los dispositivos que se ejecuten en iOS 13 y Android 7 o en versiones anteriores. Obtén más información sobre cómo usar la aplicación
Ten en cuenta que no será compatible con los dispositivos que se ejecuten en iOS 13 y Android 7 o en versiones anteriores. Obtén más información sobre cómo usar la aplicación
Sí, puedes acceder a Manual de Microbiología, guías prácticas para laboratorio de Luz Stella Ramírez Aristizábal,Luisa Fernanda Ospina Ocampo,Ángela María Arango Londoño en formato PDF o ePUB, así como a otros libros populares de Ciencias biológicas y Microbiología. Tenemos más de un millón de libros disponibles en nuestro catálogo para que explores.